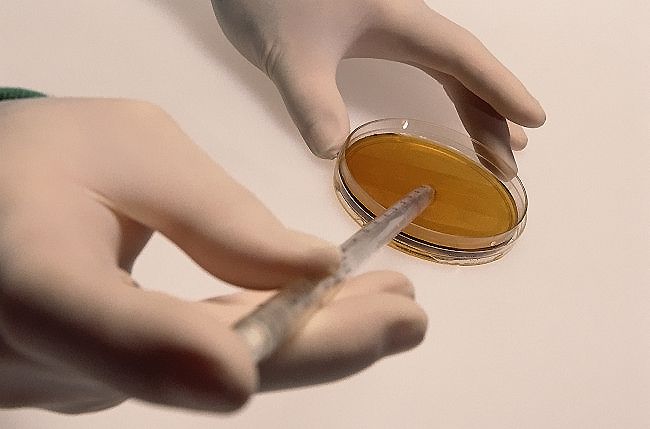

国家司法厅批准的有独立司法鉴定资格的检测机构,证件齐全;拥有国家
司法部门认证资质背书,鉴定结果具备法律效应!
与北京协和医科大学、武汉大学、复旦大学、中国医科大学等高校共同建
立了多个国内外领先的基因研发平台,不断创新以保障检测技术一直在行
业前沿!
由现代DNA亲子鉴定开创者——王教授、张教授 领衔,组建强大的DNA
检测专家团队!
华贝拥有包括从博士、硕士、海归人员在内共计300多人的司法鉴定专家
、法医学与遗传学专业团队团队规模庞大!
引进世界通过FDA临床认证的核酸质谱平台:MassARRAY
Compact Analyzer
实验室拥有Illumina公司Hiseq4000、NextSeq500二代测序仪,
Life Technologies公司3730XL、3500XL测序仪,MassARRAY飞行
时间质谱(MALDI-TOF)仪,Affymetrix 的GeneChip实验平台,罗
氏480Q-PCR仪共计近50台技术领先检测仪器。
在全国各个省份投资建立服务网点44家、检测实验室22家,方便您可以
就近找到提供服务的网点获取华贝专家的免费咨询服务。
常规DNA检测项目7天即可出报告,加急鉴定服务3小时出结果。
可为委托方提供上门采样服务、每个案例办理时间约15分钟。
专业医学服务团队提供24小时在线服务,为客户创造良好的服务体验。
华贝承诺:无论是在鉴定前还是鉴定后,我们都严格保护个人隐私,鉴
定结果绝对保密不泄漏。

汕头市华贝健康科技有限公司位于广东省汕头市金园路14号,主要从事基因检测咨询服务。检测项目分司法鉴定、健康管理,两个类别 司法:上户口亲子鉴定,司法亲子鉴定, 隐私亲子鉴定,移民亲子鉴定,胎儿亲子鉴定 ,亲缘鉴定 , 新生儿基因身份证 健康:无创产前基因,地中海贫血基因,耳聋基因,叶酸基因,肿瘤个体化用药,遗传基因,男/女癌基因,儿童天赋基因,美容抗衰老基因,儿童安全用药等基因检测等服务,常年接受来自北京,天津,上海,重庆,香港,黑龙江,辽宁,吉林,河北,河南,山东,山西,陕西,内蒙,甘肃,湖北,湖南,安徽,江苏,浙江,福建,广东,广西,四川,贵州等国内省市和地区的委托鉴定。基因检测改变生活,谛造健康人生。

大部分委托人咨询亲子鉴定的时候都会以为亲子鉴定是在医院里面进行的,其实不然,一般的医院都是没有亲子鉴定相关服务跟科室的。因为医院是医疗机构,只能提供常规的诊疗服务,而亲子鉴定...
亲子鉴定这一技术曾主要用于刑侦领域,如追凶、身份确认等案件。然而,随着基因测序技术的发展,亲子鉴定的应用已经大大扩展,如判断孩子是否亲生、给孩子办理户口、医学出生证明、异地入学...

亲子鉴定,是指运用生物学、遗传学以及有关学科的理论和 DNA 测序技术,根据遗传性状在子代和亲代之间的遗传规律,判断被控的父母和子女之间是否存在亲生关系。涉及的应用场景包...

无创胎儿亲子鉴定也叫无创产前亲子鉴定、静脉血亲子鉴定,是指通过采集孕妇静脉血,利用最新一代高通量测序技术分离出胎儿游离的DNA,然后再与男方DNA进行比对分析,从而确认胎儿与男...

做亲子鉴定需要拍照吗 ? 在进行亲子鉴定时,是否需要拍照其实要看你办理的亲子鉴定类型。一般来说,亲子鉴定分为非司法亲子鉴定和司法亲子鉴定两种,它们的办理方式和要求各有不同...

在如今这个科技日新月异的时代,亲子鉴定技术已成为解开血缘谜团的重要手段。然而,对于许多人来说,亲子鉴定仍是一个相对陌生且复杂的过程。那么,在办理亲子鉴定之前,我们应该做好哪些准...

网上可以做亲子鉴定吗?随着科技的发展,亲子鉴定变得越来越普及,尤其是在网上预约方面。然而,无论是为了个人隐私还是法律手续,亲子鉴定都涉及到复杂的流程和细节,下面我们将详细介绍如...

每到暑假,就是孩子上户口的高峰期,而想要给孩子上户口,很多人都被要求先去做个亲子鉴定,这个亲子鉴定就叫做上户口亲子鉴定。那么,给孩子上户口亲子鉴定流程是怎样? 上户...

无创 dna 亲子鉴定,也称“无创胎儿亲子鉴定”、“无创孕期亲子鉴定”、“无创产前亲子鉴定”,是利用新一代 DNA 测序技术对孕妇静脉血中的游离 DNA (包含胎...

父子关系鉴定最快方法就是做一个亲子鉴定。亲子鉴定,是指运用生物学、遗传学以及有关学科的理论和DNA测序技术,根据遗传性状在子代和亲代之间的遗传规律,判断被控的父母和子女之间是否亲...

因为不知道孩子是不是亲生的,一般都是可以做 dna 亲子鉴定的,请问,做亲子鉴定需要多久出结果 ?DNA 亲子鉴定分为个人亲子鉴定、司法亲子鉴定和孕期胎儿亲子鉴定,一...

宝宝在肚子里可以做亲子鉴定,这种亲子鉴定我们一般称为胎儿亲子鉴定或者孕期亲子鉴定、产前亲子鉴定。现在做胎儿亲子鉴定基本上都是采用无创胎儿亲子鉴定的模式,也就是当胎儿遗传意义上的...